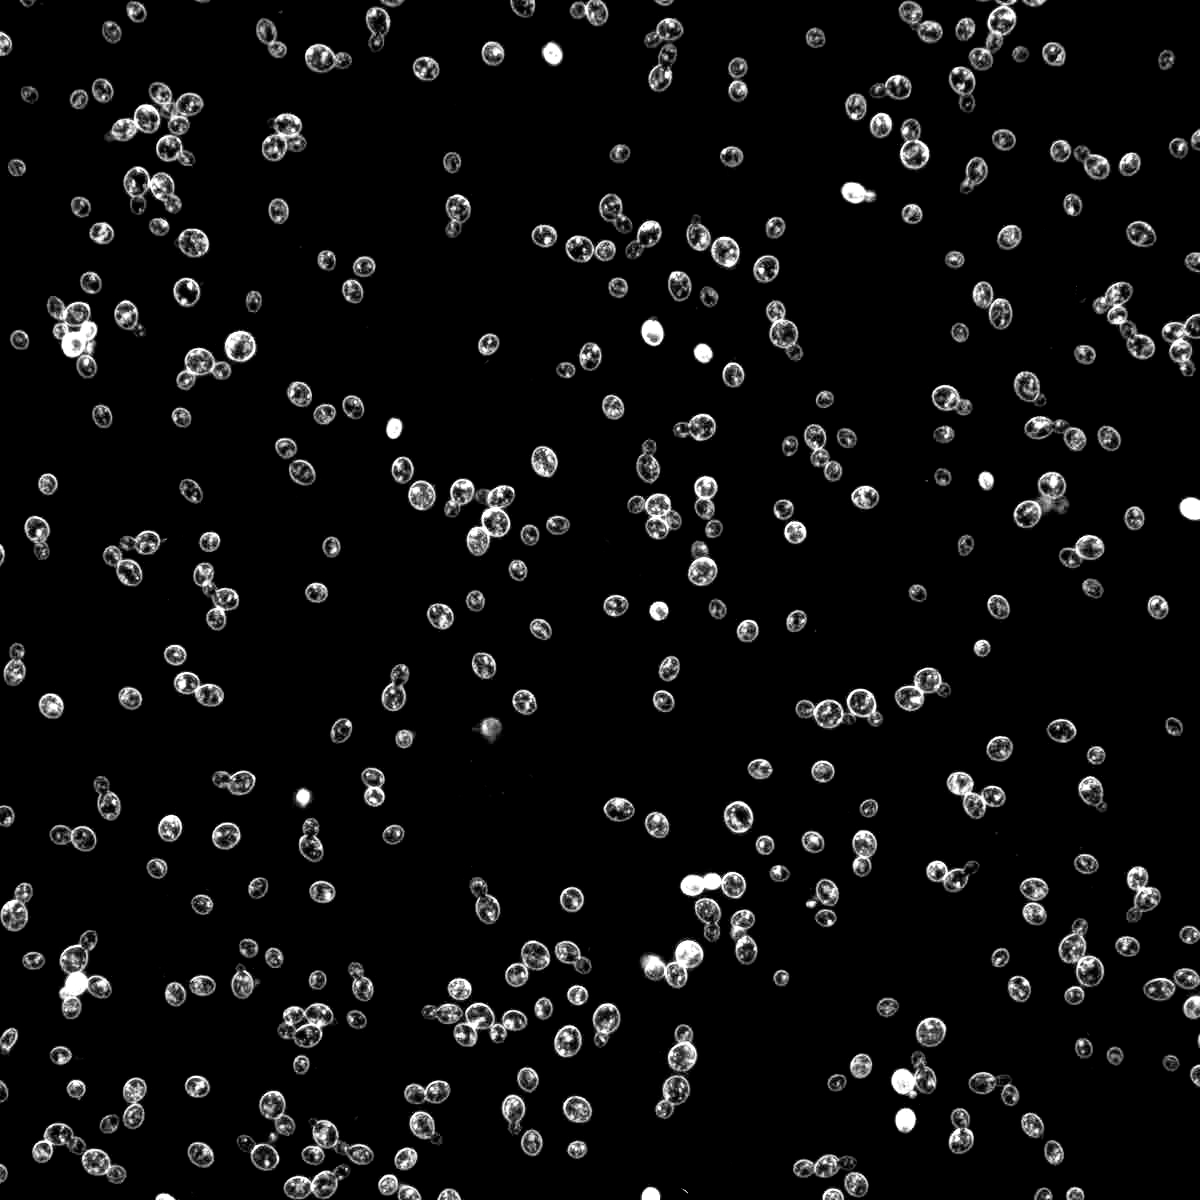
1028
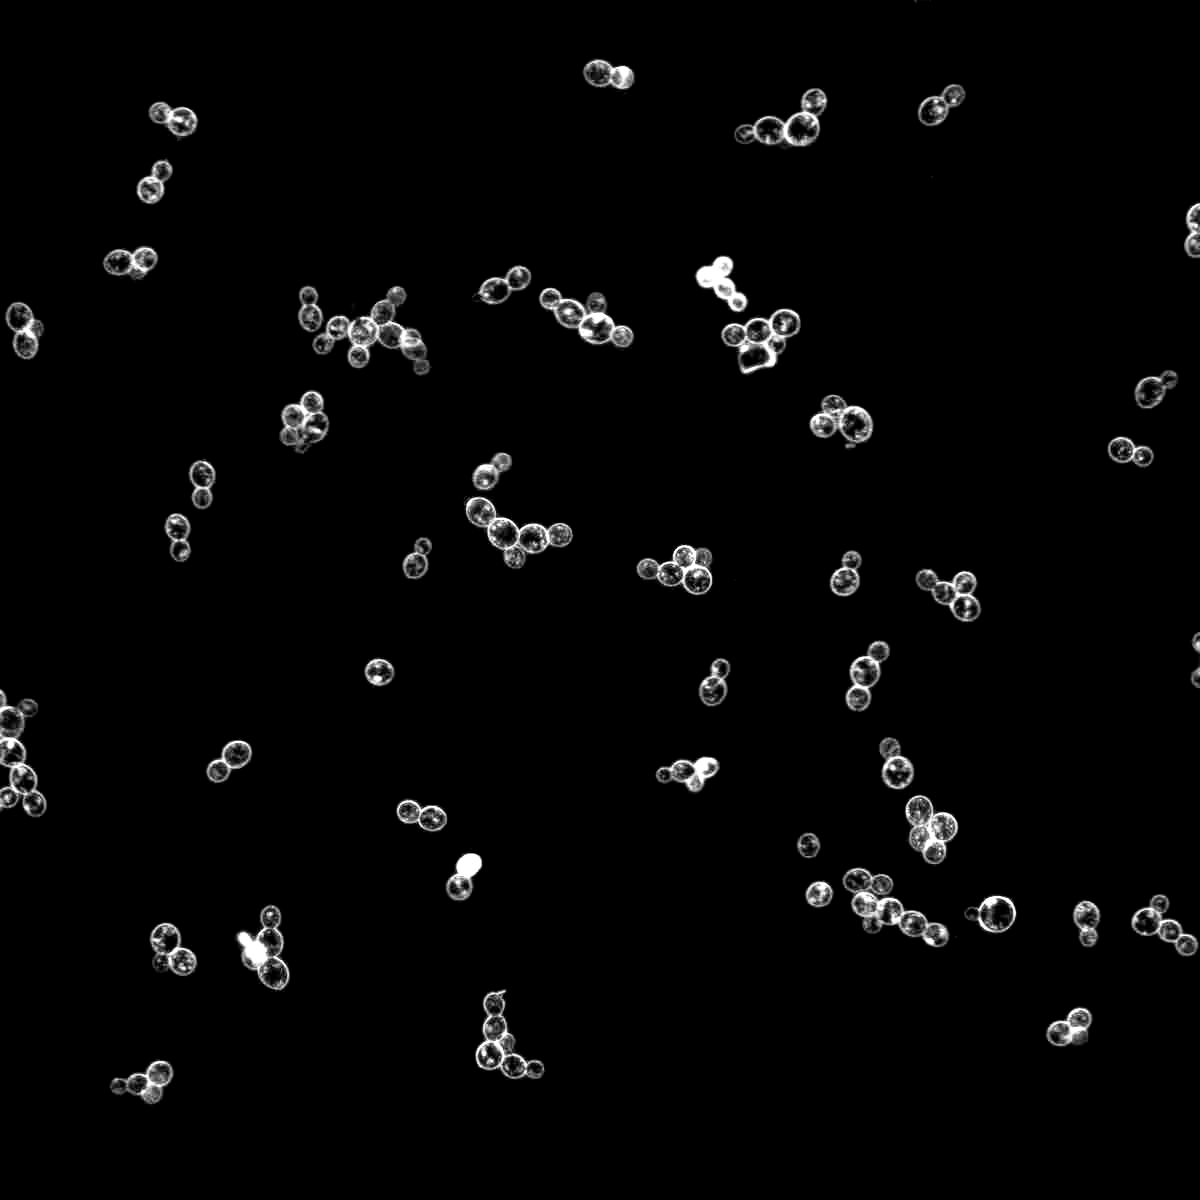
1099
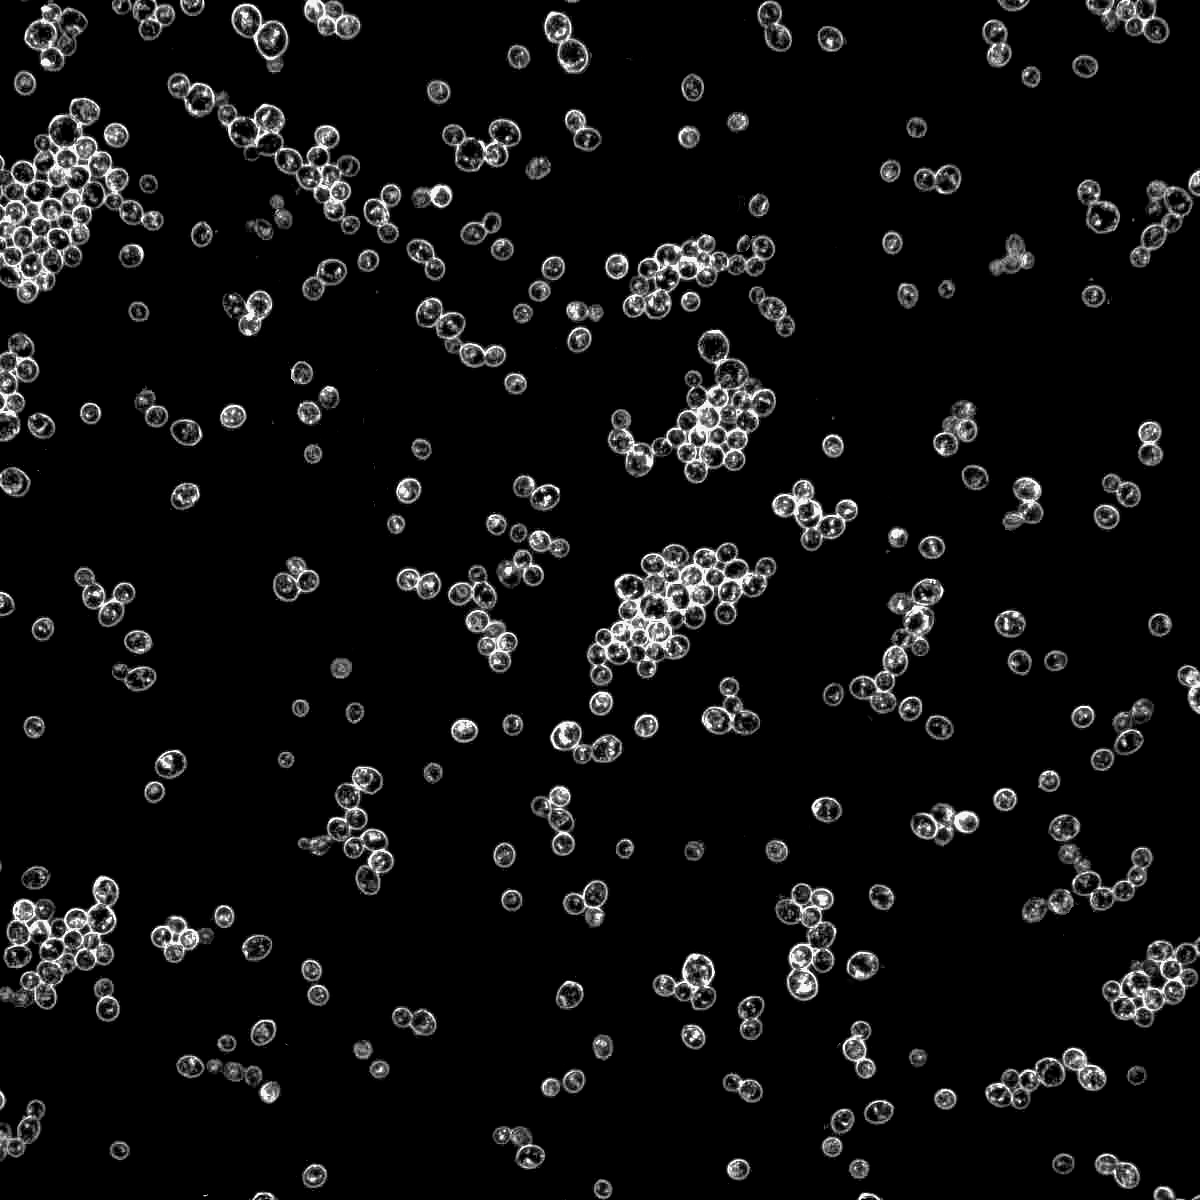
2002-PC
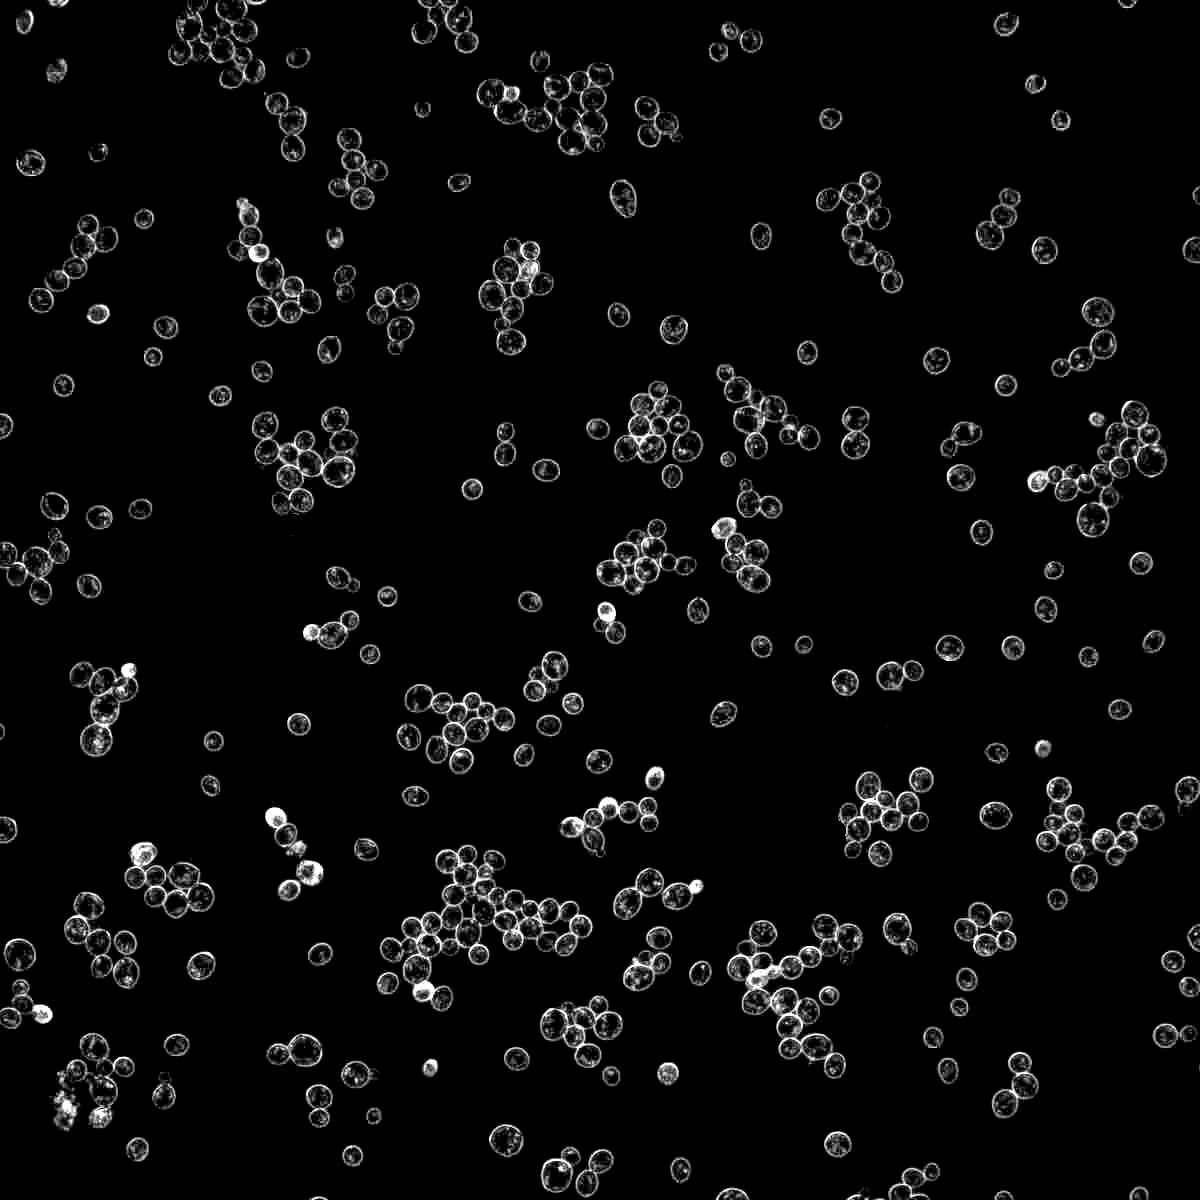
2247-PC
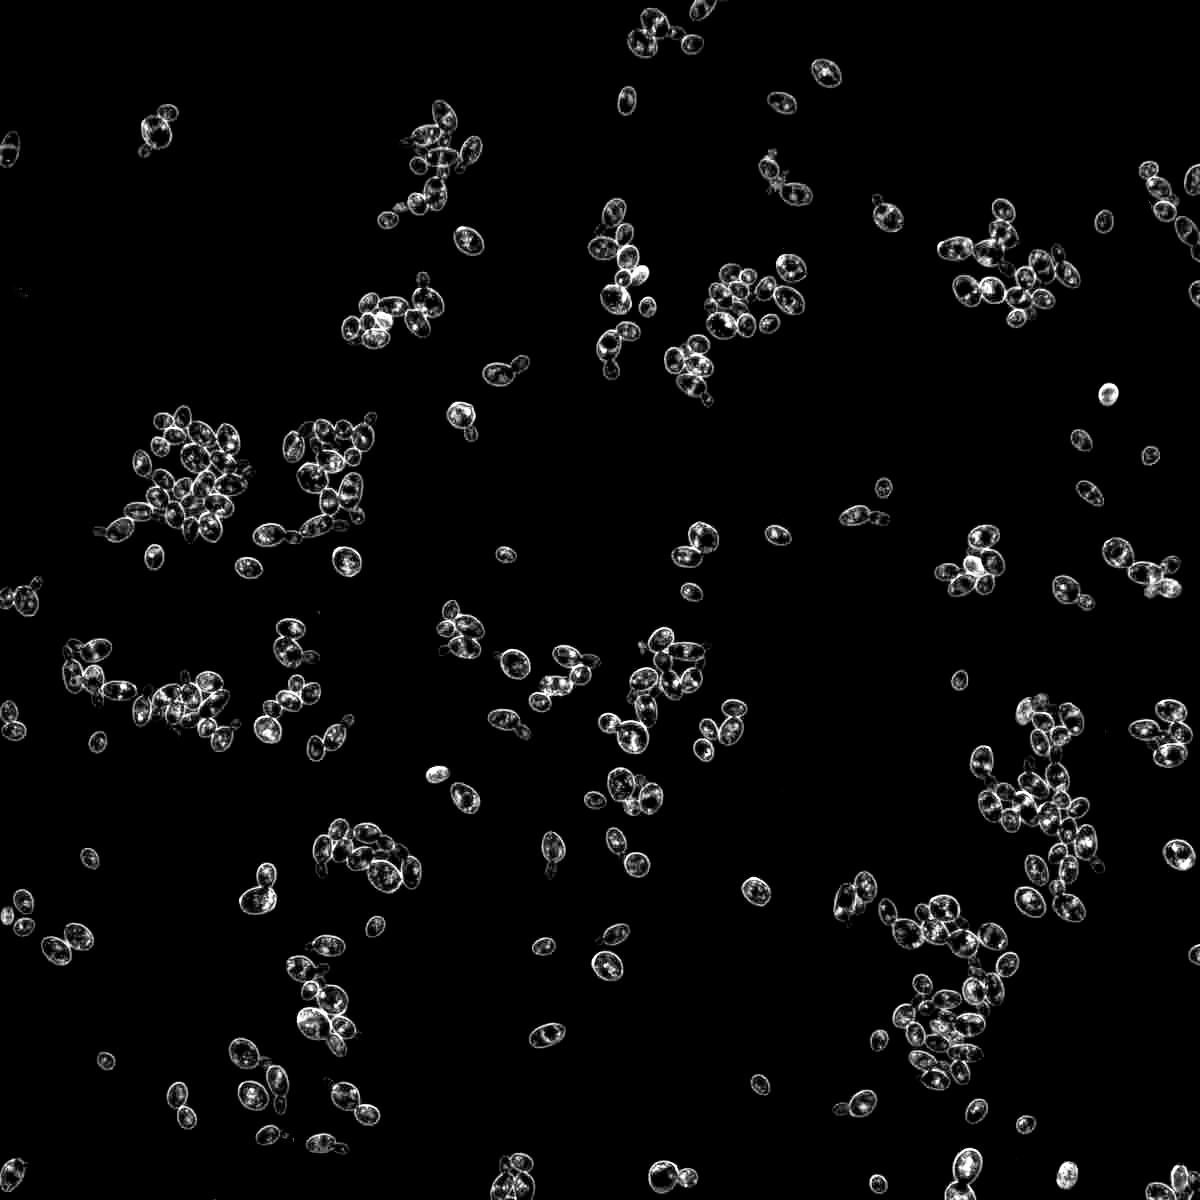
2278
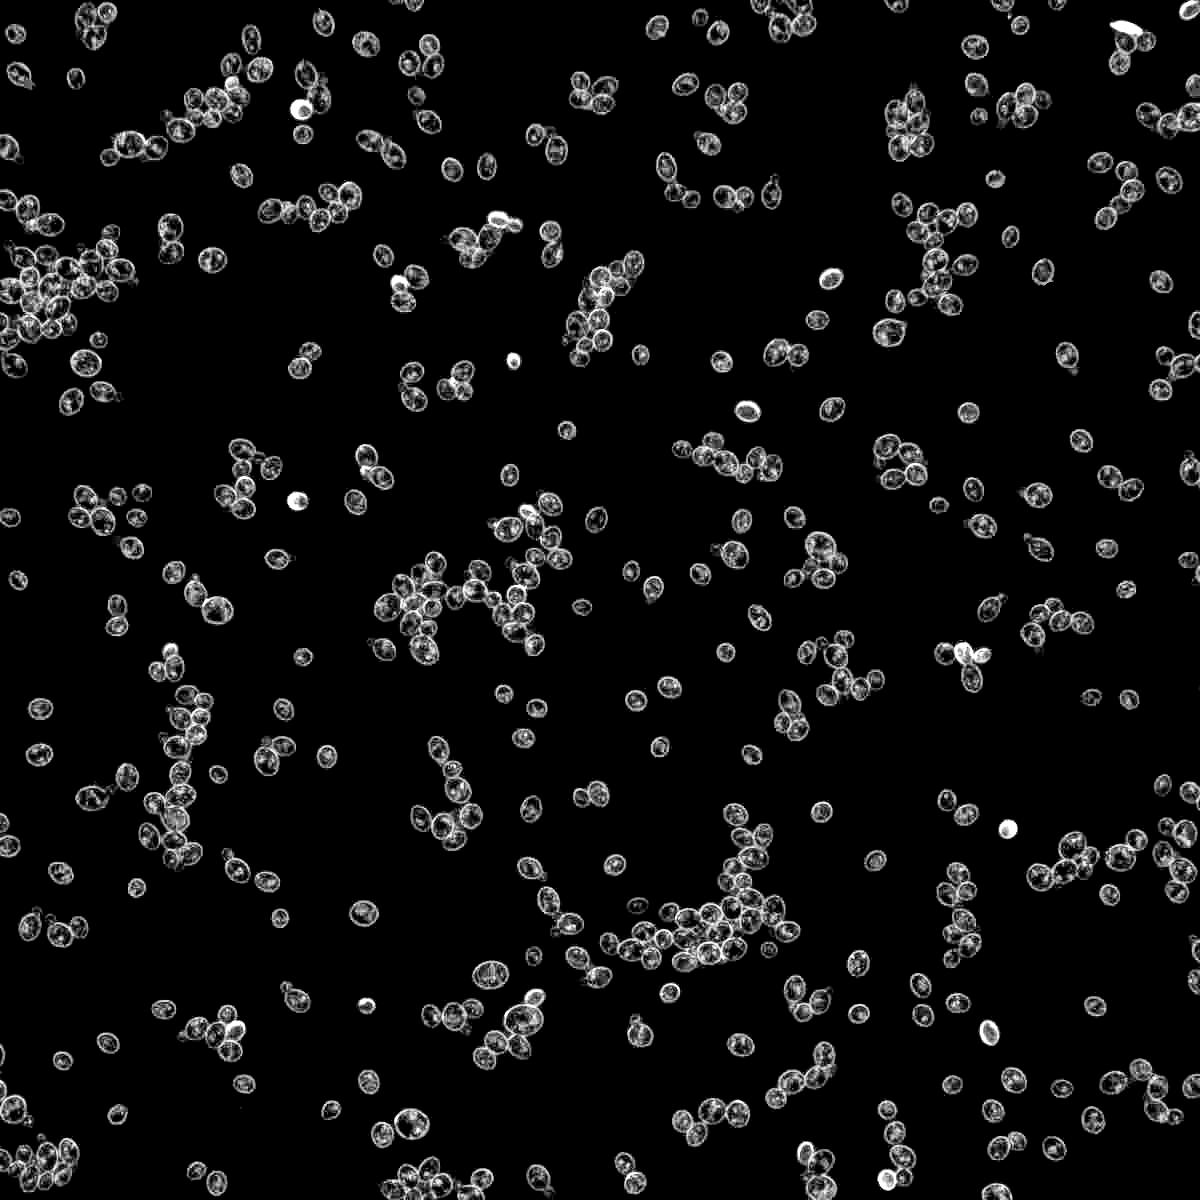
3942-PC

1007
Beer Strains
Yeast & Cultures
Learn more about brewing beer with Wyeast Premium Liquid Yeast, including useful resources for home enthusiasts and professional brewers alike.
Attenuation
Flocculation
Temperature Range
Apparent Alcohol Tolerance
Type
Strain Characteristics
Advanced search
1010
American Wheat
1026-PC
British Cask Ale
1028
London Ale
1056
American Ale®
1084
Irish Ale
1087-PC
Wyeast Bohemian Ale Blend
1098
British Ale
1099
Whitbread Ale
1187
Ringwood Ale
1203-PC
Burton IPA Blend
1214
Belgian Abbey Style Ale
1217-PC
West Coast IPA
1272
American Ale II
1275
Thames Valley Ale
1318
London Ale III
1332
Northwest Ale
1335
British Ale II
1388
Belgian Strong Ale
1450
Denny's Favorite 50
1469
West Yorkshire Ale
1581-PC
Belgian Stout
1728
Scottish Ale
1762
Belgian Abbey Style Ale II
1768-PC
English Special Bitter
1882-PC
Thames Valley Ale II
1968
London ESB Ale
2000-PC
Budvar Lager
2001-PC
Pilsner Urquell H-Strain
2002-PC
Gambrinus Style Lager
2007
Pilsen Lager
2035-PC
American Lager
2042-PC
Danish Lager
2105-PC
Rocky Mountain Lager
2112
California Lager
2124
Bohemian Lager
2206
Bavarian Lager
2247-PC
European Lager
2272-PC
North American Lager
2278
Czech Pils
2308
Munich Lager
2352-PC
Munich Lager II
2487-PC
Hella Bock Lager
2565
Kölsch
2575-PC
Kölsch II
2633
Octoberfest Lager Blend
2782-PC
Staro Prague Lager
3056
Bavarian Wheat Blend
3068
Weihenstephan Weizen
3333-PC
German Wheat
3463-PC
Forbidden Fruit
3522
Belgian Ardennes
3638
Bavarian Wheat
3655-PC
Belgian Schelde Ale
3711
French Saison
3724
Belgian Saison
3725-PC
Bière de Garde
3726
Farmhouse Ale
3739-PC
Flanders Golden Ale
3787
Belgian High Gravity
3822-PC
Belgian Dark Ale
3864-PC
Canadian/Belgian Ale
3942-PC
Belgian Wheat
3944